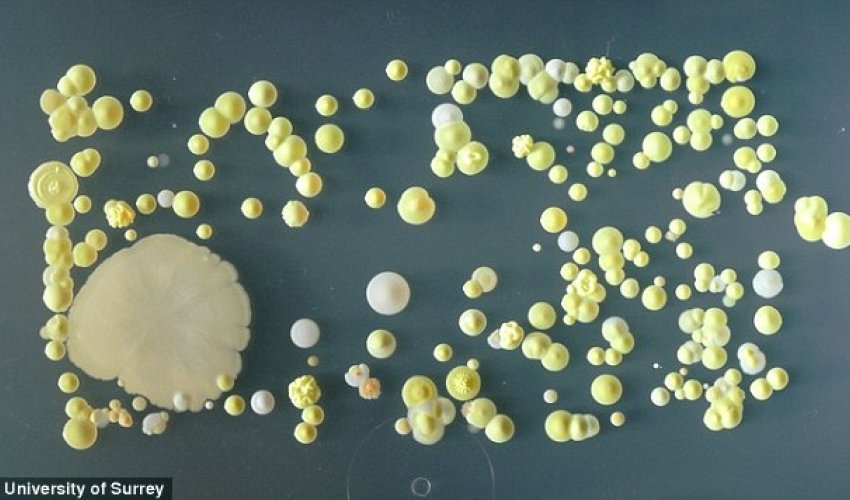
How filthy is YOUR phone?

How filthy is YOUR phone?
If you’re rarely without your smartphone, then chances are that it’s teeming with bacteria - as seen in this collection of alarming photos.
In many cases, this bacteria is relatively harmless and comes from touching unclean surfaces or not washing your hands properly.
But in others, the bacteria found can lead to infections such as food poisoning, impetigo and even septicaemia.
To study the level of dirt on a person’s phone, students studying bacteriology at the University of Surrey imprinted their mobile phones on to so-called ‘bacterial growth medium’ in Petri dishes.
On a number of occasions, the disease-carrying bacteria Staphylococcus aureus was discovered.
It is thought that 20 per cent of people are long-term carriers of the bug, which often lurks inside the nasal passages.
Many healthy people carry these bacteria on their skin and in their noses without getting sick.
But when skin is punctured or broken, staph bacteria can enter the wound and cause infections.
It is a common cause of Staph infections including food poisoning, impetigo and even septicaemia.
And Staph bacteria can easily spread through contaminated surfaces and from person to person.
Another bacteria spotted was Bacillus mycoides.
This bacteria is typically found in soil, which suggests the phone or its user had been in contact with soil recently.
Bacillus mycoides are found in common pesticides and are used to inhibit the growth of harmful bacteria and fungi.
Dr Park said: 'It seems that the mobile phone doesn’t just remember telephone numbers, but also harbours a history of our personal and physical contacts such as other people, soil and other matter'
'As part of [the course] I get the students to imprint their mobile phones on to bacteriological growth Petri dishes so that we might determine what they might carry.
'It's unusual, but a very effective way of engaging our students with the often overlooked microbiology of everyday life.
'The ecological niche on the body for Staphylococcus aureus is the nostrils, so a furtive pick of the nose, and quick text after, and you end up with this pathogen on your smartphone.
The average handset carries 18 times more potentially harmful germs than a flush handle in a men's toilet, recent tests revealed.
An analysis of handsets found almost a quarter were so dirty that they had up to ten times an acceptable level of bacteria.
One of the phones in the test had such high levels of bacteria it could have given its owner a serious stomach upset.
The findings from a sample of 30 phones by Which? magazine suggest 14.7million of the 63million mobiles in use in the UK today could be potential health hazards.
(dailymail.co.uk)
ANN.Az




Similar news
Similar news
Latest news 
More news 



































 Photo
Photo 



 Video
Video 

